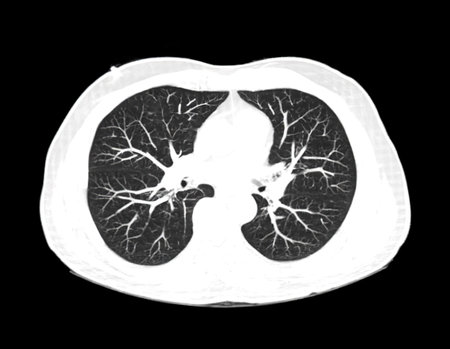
CT scan of Chest or lung  axial view at radiology department in hospital. Covid-19 scan body xray test detection for covid virus epidemic spread conceptの写真素材

写真素材 - CT scan of Chest or lung axial view at radiology department in hospital. Covid-19 scan body xray test detection for covid virus epidemic spread concept
作品情報
CT scan of Chest or lung axial view at radiology department in hospital. Covid-19 scan body xray test detection for covid virus epidemic spread concept
- ID:199431726
- 作品種別:写真
- 作者名:Suphachai praserdumrongchai
キーワード
- anatomy
- angiogram
- aorta
- aortic
- background
- cardiac
- cardiology
- cardiovascular
- check
- chest
- chest scan
- computed
- computed tomography
- contrast media
- coronavirus
- covid19
- ct chest
- ct heart
- ct scan
- ct scan of chest
- diagnostic
- disease
- examination
- health
- hospital
- human
- imaging
- infection
- injection
- lung
- lung cancer
- lung disease
- lungs
- medical
- pain
- pandemic
- patient
- pneumonia
- procedure
- pulmonary
- pulmonary embolism
- radiography
- respiratory
- scan
- science
- study
- test
- thorax
- tomography
- tuberculosis
類似作品
chest X-rays un...
Interesting X-R...
The MRI or CT s...
Doctor looking ...
X-Ray Image Of ...
Doctor checking...
Doctor examinin...
Human Lungs Rad...
science anatomy...
chest x-ray exa...
Respiratory org...
close up x-ray ...
CT scan of Ches...
Cheat xray of a...
Medical monitor...
Lungs show vibr...
An x-ray image ...
The MRI or CT s...
3d rendered ill...
Silhouette of a...
film chest x-ra...
Close up detail...
MRI of the uppe...
Radiologist loo...
chest X-rays un...
Lungs Human Res...
Lung cancer ( C...
X-ray human lun...
X-ray of the hu...
Image of diseas...
Tumor. Lung can...
Pulmonary Tuber...
Radiologist loo...
Tomography of t...
Lung green tree...
woman doctor in...
X-ray of human ...
close up x-ray ...
xray film of a ...
Man doctor look...
x-ray of human ...
Futuristic Arti...
Scoliosis ( cro...
CT scan of Ches...
3D colorful ill...
Doctor attentiv...
A CTA pulmonary...
Doctor holding ...
Chest xray in P...